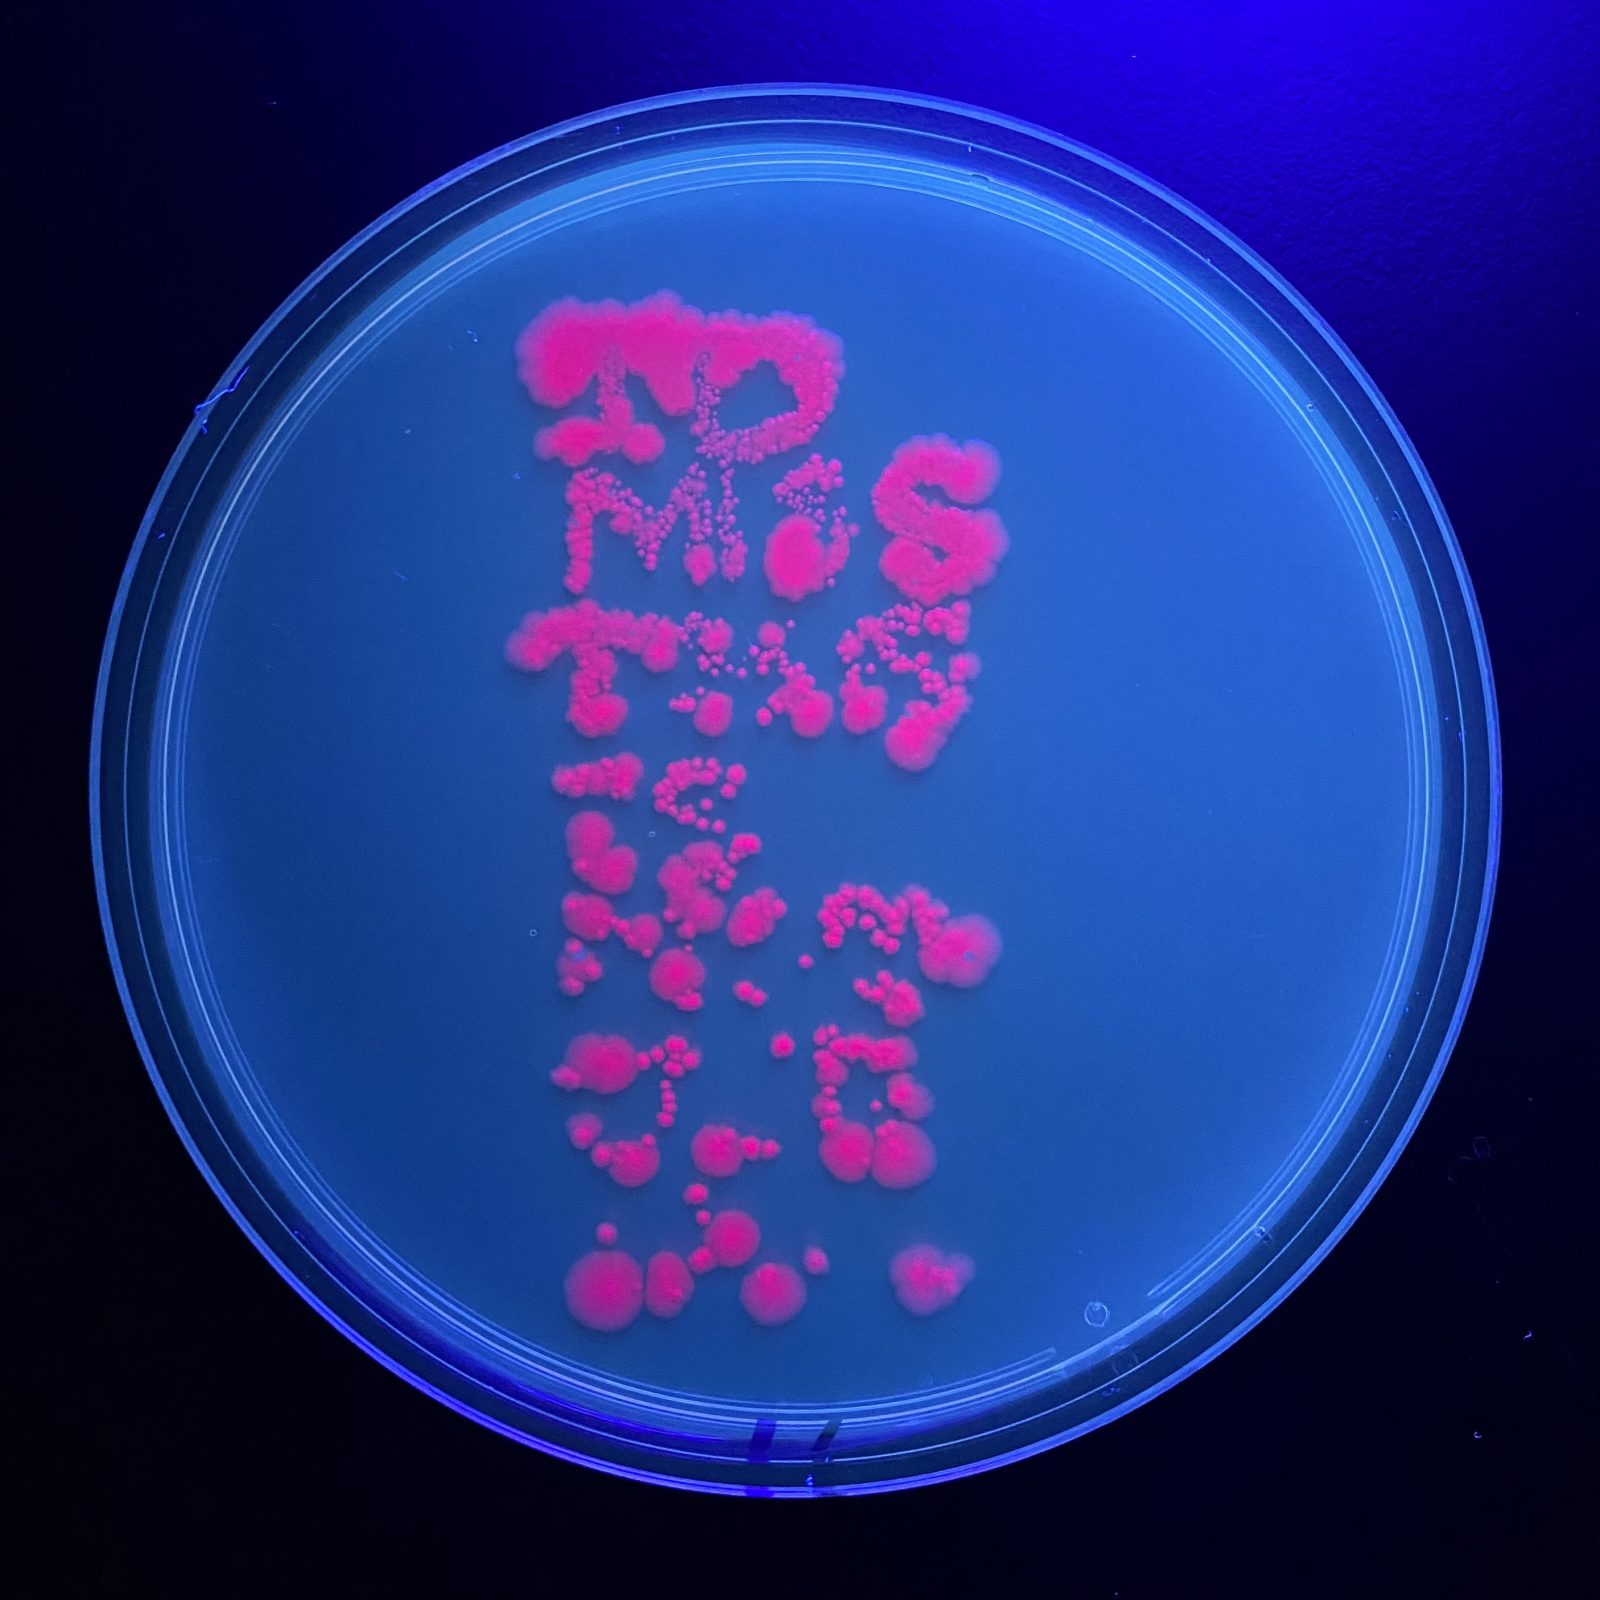

mycelium Project Overview I was so incredibly excited to work with mycelium, it’s a material that has been all the…
bacterial cellulose project Project Overview I am really interested in sustainable fashion design, especially when it incorporates any making of…
bacterial printing project Project Overview The most exciting thing to me during this first project in the lab was finding…
My absolute favorite thing to photograph is tree branches in the winter when you can really see them twisting and tangling. This is a mini display of interspecies connectivity (?).
I really wanted to make pasta, so I did. I thought it would be funny to serve a dish that was inedible but looked edible, or mimicked food.
I wanted to play on cake-related ideas I had previously explored in another project. In this mycelium version, the focus was more on the humor. The concept was a cake that would grow its own frosting.(incomplete/did not grow all the way)
put your 50 word project sttement here
put your 50 word project sttement here
memento, 2025.
cast mycelium growth (work in progress).
…, 2025
bacterial cellulose, rust-dyed bacterial cellulose, rusted steel, rust-dyed string.
to miss this is not useless, 2025
timelapse of genetically engineered e. coli growth; series of inscriptions in RFP e. coli, amajlime e.coli, rusted steel, rust print on cheesecloth
Bacterial Cellulose printed linocut
Nicholas Mittman, Interdisciplinary Sculpture, 2027 Interdisciplinary Sculpture major at MICA. Originally transferred from Harford Community College; Nicholas enjoys working with…
Nicholas Mittman, Interdisciplinary Sculpture, 2027 Interdisciplinary Sculpture major at MICA. Originally transferred from Harford Community College; Nicholas enjoys working with…
Nicholas Mittman, Interdisciplinary Sculpture, 2027 Interdisciplinary Sculpture major at MICA. Originally transferred from Harford Community College; Nicholas enjoys working with…
box made from reishi mycelium grown on wood pellets.
Hanging sculpture made with reishi mycelium, soldered reclaimed glass, bridal veil, mussel shell pigment, wood.
Mycelium, wood, and wire.
put your 50 word project sttement here
“FLAG 1”, structure made from sourced oak twigs and hemp cord with cellulose with a dried flower inclusion.
Creating a structure for mycelium to grow and expand, closing the gaps, and giving the structure more of a form.
bacterial printing with multiple colors.
Llatra, or llata, is a traditional basket weaving in Mallorca. This project is an experiment to see if it’s possible to make llatra with bacterial cellulose.
Illustrated Manuscript on Bacterial Cellulose detailing Vaginoplasty, Functions as Corset
“As the Mother, So the Child”
Lab-grown bacterial cellulose formed into a tatted lace border on fabric with a wintergreen transfer.